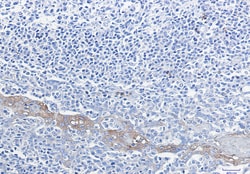
Invitrogen G6PD Recombinant Rabbit Monoclonal Antibody (K01_1R70) 50 &mu;L | Buy Online | Invitrogen&trade; | Fisher Scientific

missing translation for 'onlineSavingsMsg'
Learn More
Learn More
Invitrogen™ G6PD Recombinant Rabbit Monoclonal Antibody (K01_1R70)
Description
G6PD Recombinant Monoclonal Antibody for IHC (P), Western Blot
This gene encodes glucose-6-phosphate dehydrogenase. This protein is a cytosolic enzyme encoded by a housekeeping X-linked gene whose main function is to produce NADPH, a key electron donor in the defense against oxidizing agents and in reductive biosynthetic reactions. G6PD is remarkable for its genetic diversity. Many variants of G6PD, mostly produced from missense mutations, have been described with wide ranging levels of enzyme activity and associated clinical symptoms. G6PD deficiency may cause neonatal jaundice, acute hemolysis, or severe chronic non-spherocytic hemolytic anemia. Two transcript variants encoding different isoforms have been found for this gene.

Specifications
Specifications
| Antigen | G6PD |
| Applications | Immunohistochemistry (Paraffin), Western Blot |
| Classification | Recombinant Monoclonal |
| Clone | K01_1R70 |
| Concentration | 1 mg/mL |
| Conjugate | Unconjugated |
| Formulation | 50mM tris glycine with 150mM NaCl, 40% glycerol, 0.05% BSA and 0.01% sodium azide; pH 7.4 |
| Gene | G6PD |
| Gene Accession No. | P05370, P11413 |
| Gene Alias | G28A; G6PD; G6PD1; G6pd-1; G6pdx; Glucose-6-phosphate 1-dehydrogenase; glucose-6-phosphate 1-dehydrogenase X; glucose-6-phosphate dehydrogenase; glucose-6-phosphate dehydrogenase X-linked; Gpdx |
| Show More |
Product Title
By clicking Submit, you acknowledge that you may be contacted by Fisher Scientific in regards to the feedback you have provided in this form. We will not share your information for any other purposes. All contact information provided shall also be maintained in accordance with our Privacy Policy.
Spot an opportunity for improvement?